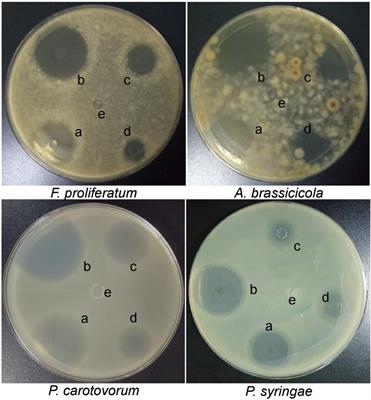

Original Research
Published on 04 Dec 2025
The bacterial species’ degradation activities at maximum threshold doses of glyphosate across different pH levels and temperature glyphosate biodegradation by soil bacteria at high doses under variable pH and temperature
in Microbiotechnology
- 2,249 views